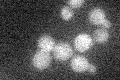
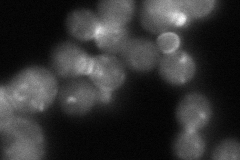
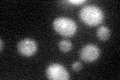

View description
Protein required for beta-1,6 glucan biosynthesis; putative beta-glucan synthase; appears functionally redundant with Skn1p
Localization:
Intensity:
Fold change:
Significance:
-
C’ GFP library in SD
below threshold14.65 -
N' NOP1pr-GFP in SD
punctate,bud neck92.5033 -
N' TEF2pr-mCherry in SD

cell periphery,vacuole,bud43.1396 -
N' NATIVEpr-GFP in SD

punctate,bud40.9673 -
N' TEF2pr-VC and Cyto-VN in SD

below threshold30.4674 -
C’ GFP library in SD+DTT
cytosol15.11.03No -
C’ GFP library in SD+H2O2

cytosol16.071.09No -
C’ GFP library in Starvation Media

cytosol16.471.12No -
C’ GFP library on the background of Pup2-DaMP

below threshold -
C’ GFP library on the background of CCT mutant

below threshold13.82630.94309No
